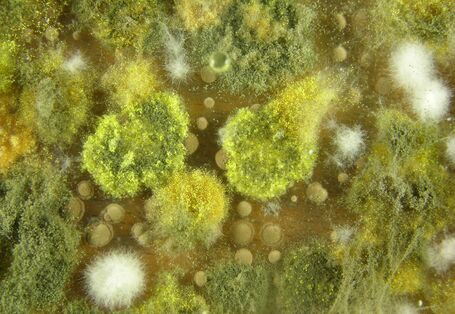
mould

Environmental justice – Environment, health and social conditions

People with low incomes and little education are often more exposed to environmental stress than socially advantaged people. Under the heading of “environmental justice”, the UBA works on the subject of the (uneven) distribution of exposure to environm. pressures and environmental resources and its health implications, with the aim of helping to create healthy environmental and living conditions.